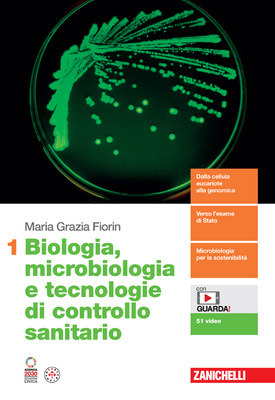

Dalla cellula eucariote alla microbiologia per la salute e l’ambiente
- Le cellule procariote hanno una struttura più semplice di quelle eucariote, ma una straordinaria varietà di abilità metaboliche che permettono loro di adattarsi a qualunque ambiente.
Verso l’esame di Stato
- Per prepararsi alla seconda prova dell’esame di Stato è utile allenarsi di anno in anno. Alla fine di ogni capitolo, uno o più esercizi mettono alla prova le competenze acquisite con problemi e quesiti da risolvere.
Microbiologia per la sostenibilità
- I microrganismi procarioti e i virus possono aiutarci a capire meglio gli ecosistemi in cui viviamo e sono utili alleati per risolvere problemi ambientali e di salute pubblica. Le biotecnologie sfruttano da secoli i microbi e negli ultimi settant’anni questa ricerca ha fatto passi da gigante.
LaZ Ebook L’ebook multimediale dei volumi + le risorse digitali
Altre proposte nel sito del libro: online.scuola.zanichelli.it/fiorin2ed
In sintesi:
- Dalla cellula eucariote alla microbiologia per la salute e l’ambiente
- Verso l’esame di Stato
- Microbiologia per la sostenibilità
- con GUARDA! 60 video